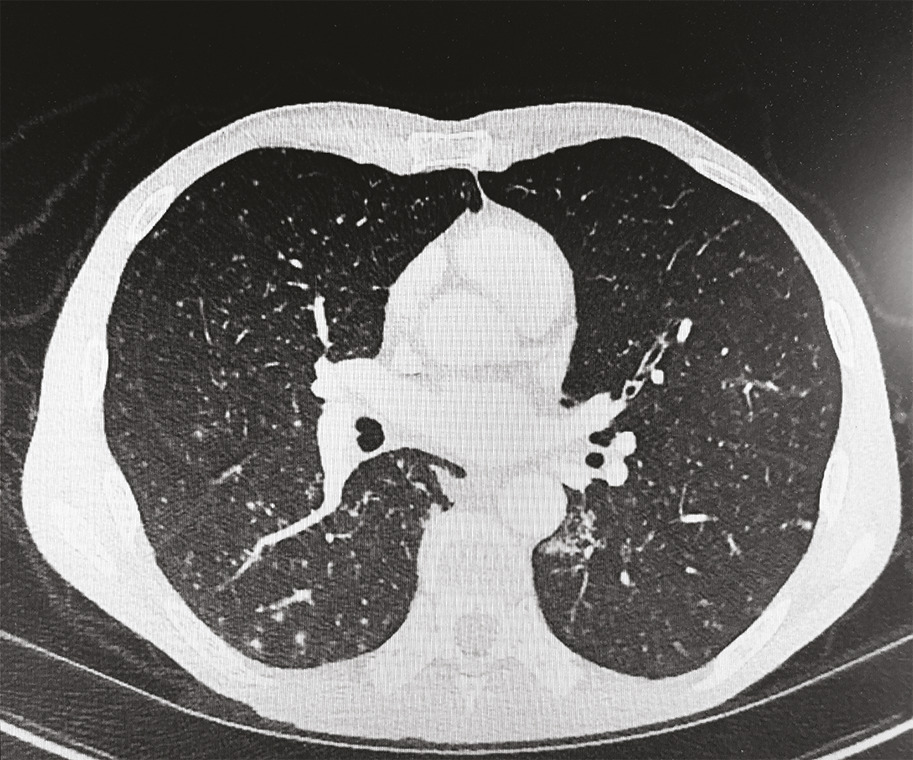

Cet homme de 56 ans vivant avec le VIH et en rupture thérapeutique, était adressé pour une gingivite ulcéro-nécrotique (
Le patient a bénéficié d’une quadrithérapie initiale (isoniazide, rifampicine, pyrazinamide, éthambutol), au cours de laquelle les thérapeutiques antirétrovirales ont pu être réinstaurées, suivie d’une bithérapie (isoniazide, rifampicine). Les symptômes oraux ont régressé sous traitement et un contrôle à 4 mois a confirmé une nette amélioration.
La tuberculose comporte des formes extrapulmonaires, dont 0,1 à 5 % de localisations orales. Ces dernières, méconnues, revêtent un aspect atypique, responsable d’une errance diagnostique et d’un retard de prise en charge.1
Les lésions peuvent être primaires, caractérisées par des ulcérations associées à des adénopathies cervicales, ou plus souvent secondaires, par inoculation directe, via les crachats bacillifères, ou diffusion hématogène. L’atteinte linguale reste la plus fréquente, mais celle du palais, des lèvres et de la gencive s’observe aussi ; l’ulcération est la lésion la plus commune, mais nodules, tuberculomes voire ostéomyélites sont possibles.2
La tuberculose orale implique une prise en charge multidisciplinaire en urgence. Les traitements adéquats peuvent permettre d’obtenir une rémission.
1. OMS, Organisation mondiale de la santé. Rapport sur la tuberculose dans le monde [en ligne]. 2019. Disponible sur : https://www.who.int/tb/publications/global_report/gtbr2019_ExecutiveSummary_fr.pdf
2. Jain P, Jain I. Oral manifestations of tuberculosis: step towards early diagnosis. J Clin Diagn Res. 2014;8:ZE18-21.
Une question, un commentaire ?